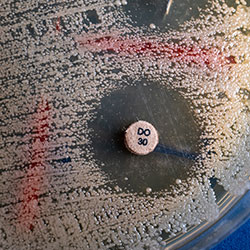

A new test is harnessing CRISPR to detect urinary tract infections and identify which antibiotics to treat them.

Researchers have successfully adapted a CRISPR-based diagnostic platform to rapidly identify common urinary tract pathogens and key antimicrobial resistance (AMR) genes directly from urine, offering a potential alternative to culture-dependent testing that can delay targeted therapy.
The work, which was presented as abstract P-798 at IDWeek 2025, in Atlanta, expands the platform usage beyond bloodstream infections.
“Antimicrobial resistance is one of the most urgent challenges in global health, responsible for over 1.2 million deaths each year,” said Bhrus Sangruji, the study’s lead author. “The problem is especially severe in low- and middle-income countries where diagnostic resources are limited.”
How It Works
The BADLOCK platform—which stands for Bacterial and AMR Detection by SHERLOCK—uses a CRISPR-Cas13a–based SHERLOCK system combined with recombinase polymerase amplification in a one-pot, isothermal reaction. In its original form, the platform was designed for rapid detection of pathogens and resistance genes from positive blood cultures.
“Building on BADLOCK’s success, this study aimed to extend the platform to urinary tract infections, evaluating whether it could directly detect bacteria and antimicrobial resistant markers in urine,” Sangruji said. The study was completed as Sangruji’s senior thesis at Tufts University, in Boston, building on his prior work as a visiting undergraduate researcher at the Broad Institute.
In order to simulate clinical conditions, investigators spiked pooled human urine with clinically relevant concentrations of common uropathogens, including Escherichia coli, Klebsiella pneumoniae, Enterobacter cloacae, Citrobacter freundii, and Pseudomonas aeruginosa, as well as isolates carrying resistance determinants such as CTX-M-15, KPC-2, NDM-1, and OXA-48. Multiple optimization strategies were evaluated, including increased template volume, reagent adjustments, and lysis methods.
“After testing several optimization strategies to refine the assay for urine-based detection, we found the platform could successfully identify key uropathogens and AMR genes at clinically relevant levels,” Sangruji said. Concentrating samples by centrifugation followed by heat lysis produced the most consistent performance improvements.
High Accuracy Ratings
Using the optimized workflow, the BADLOCK panel achieved 98.8% accuracy for bacterial species identification and 96.2% accuracy for AMR gene detection. All discordant results were resolved on repeat testing, and specificity remained high across targets. Importantly, the full diagnostic process produced actionable results within approximately 1.5 hours.
“With these refinements, detection accuracy reached nearly 99% for bacterial species and 96% for resistance,” Sangruji said.
“Low costs and flexible readouts make [the platform] suitable for both hospital laboratories and decentralized resource-limited clinics,” Sangruji said. “This approach supports faster, more targeted treatment decisions for clinicians … [and] is an important step towards reducing unnecessary antibiotic use and slowing the global threat of resistance.”
Sangruji reported no relevant financial disclosures.